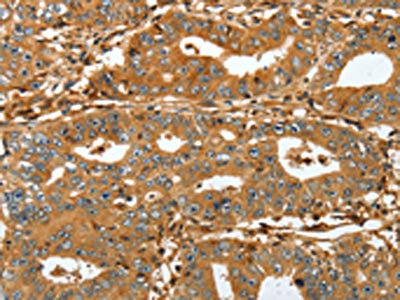

-
中文名稱:RAP1A兔多克隆抗體
-
貨號:CSB-PA968243
-
規格:¥1100
-
圖片:
-
The image on the left is immunohistochemistry of paraffin-embedded Human gastric cancer tissue using CSB-PA968243(RAP1A Antibody) at dilution 1/45, on the right is treated with fusion protein. (Original magnification: ×200)
-
The image on the left is immunohistochemistry of paraffin-embedded Human lung cancer tissue using CSB-PA968243(RAP1A Antibody) at dilution 1/45, on the right is treated with fusion protein. (Original magnification: ×200)
-
Gel: 12%SDS-PAGE, Lysate: 40 μg, Lane 1-2: Mouse brain tissue and A431 cell, Primary antibody: CSB-PA968243(RAP1A Antibody) at dilution 1/200 dilution, Secondary antibody: Goat anti rabbit IgG at 1/8000 dilution, Exposure time: 10 seconds
-
-
其他:
產品詳情
-
Uniprot No.:
-
基因名:
-
別名:C21KG antibody; G 22K antibody; G-22K antibody; GTP binding protein smg p21A antibody; GTP-binding protein smg p21A antibody; KREV 1 antibody; KREV1 antibody; OTTHUMP00000013741 antibody; RAP 1A antibody; RAP1 antibody; RAP1A antibody; RAP1A member of RAS oncogene family antibody; RAP1A_HUMAN antibody; Ras related protein Krev 1 antibody; Ras related protein Rap 1A antibody; RAS related protein RAP1A antibody; Ras-related protein Krev-1 antibody; Ras-related protein Rap-1A antibody; SMGP21 antibody
-
宿主:Rabbit
-
反應種屬:Human,Mouse,Rat
-
免疫原:Full length fusion protein
-
免疫原種屬:Homo sapiens (Human)
-
標記方式:Non-conjugated
-
抗體亞型:IgG
-
純化方式:Antigen affinity purification
-
濃度:It differs from different batches. Please contact us to confirm it.
-
保存緩沖液:-20°C, pH7.4 PBS, 0.05% NaN3, 40% Glycerol
-
產品提供形式:Liquid
-
應用范圍:ELISA,WB,IHC
-
推薦稀釋比:
Application Recommended Dilution ELISA 1:2000-1:5000 WB 1:500-1:2000 IHC 1:50-1:200 -
Protocols:
-
儲存條件:Upon receipt, store at -20°C or -80°C. Avoid repeated freeze.
-
貨期:Basically, we can dispatch the products out in 1-3 working days after receiving your orders. Delivery time maybe differs from different purchasing way or location, please kindly consult your local distributors for specific delivery time.
-
用途:For Research Use Only. Not for use in diagnostic or therapeutic procedures.
相關產品
靶點詳情
-
功能:Induces morphological reversion of a cell line transformed by a Ras oncogene. Counteracts the mitogenic function of Ras, at least partly because it can interact with Ras GAPs and RAF in a competitive manner. Together with ITGB1BP1, regulates KRIT1 localization to microtubules and membranes. Plays a role in nerve growth factor (NGF)-induced neurite outgrowth. Plays a role in the regulation of embryonic blood vessel formation. Involved in the establishment of basal endothelial barrier function. May be involved in the regulation of the vascular endothelial growth factor receptor KDR expression at endothelial cell-cell junctions.
-
基因功能參考文獻:
- HL-60 neutrophil-like cells expressing Rap1a(G12V) or Radil have an elongated phenotype because of enhanced uropod adhesion as they attempt to migrate on fibronectin. This elongated phenotype driven by Rap1a(G12V) or Radil is reversed by Galphai1(Q204L), but not by WT Galphai1 expression, suggesting that Galphai-GTP also regulates adhesion in immune cells at the level of, or downstream of, Radil. PMID: 29259127
- Study identifies Epac2-Rap1 signaling as a novel feedback mechanism in the heart, which controls mitochondrial reactive oxygen species production. PMID: 27649969
- Data show that the Epac-Rap1 signaling axis is involved in triapine resistance. PMID: 27602951
- Ubc9 is an essential regulator of ADAP where it is required for TCR-induced membrane recruitment of the small GTPase Rap1 and its effector protein RapL. PMID: 29127148
- These findings provide the first evidence linking Rap1A with ovarian cancer development through the ERK/p38 and Notch signaling pathways, indicating that Rap1A may be used as a novel diagnostic marker or a therapeutic target for ovarian cancer. PMID: 27925454
- High RAP1 expression is associated with neuroblastoma. PMID: 28456710
- Rap1 mediates the effects of increased extracellular tension in multiple ways that are capable of contributing to tumor progression when dysregulated. PMID: 27199371
- Novel mutations in RASGRP2, which encodes CalDAG-GEFI, abrogate Rap1 activation, causing platelet dysfunction PMID: 27235135
- Unlike Rap1B, phosphorylation in the polybasic region of Rap1A does not detectably inhibit its prenylation or its binding to SmgGDS-607. PMID: 27760305
- SHANK1 and SHANK3 act as integrin activation inhibitors by sequestering active Rap1 and R-Ras via the SPN domain and thus limiting their bioavailability at the plasma membrane. PMID: 28263956
- These results suggest that Rap1 activation of ERKs requires PKA phosphorylation and KSR binding. PMID: 28003362
- These data suggested that HBV-infection could up-regulate the expression of miR-203a, thus down regulated the expression of Rap1a. PMID: 27780730
- Studies indicate that Rap interacting proteins decide the subcellular localization of Rap, and the interaction modes with downstream Rap effectors. PMID: 27322838
- These findings provide further evidence that a crucial role for miR-203 in inhibiting metastasis of PCa through the suppression of Rap1A expression. PMID: 25636908
- Our findings suggest that RAP1 may be a useful biomarker for the diagnosis of ical intraepithelial neoplasia . PMID: 25856570
- RAP1-mediated MEK/ERK pathway defects in Kabuki syndrome. PMID: 26280580
- Rap1 knockdown attenuates prostacyclin (PC)-induced vascular endothelial cell (EC) monolayer recovery. PMID: 25545047
- Data indicate that through GTPase-activating proteins ArhGAP29 complex formation Rap1 GTP-binding protein spatially restricts Rho-mediated signaling, which is necessary for endothelial barrier potentiation. PMID: 25963656
- The direct interaction between Zscan4 and Rap1 may explain how Zscan4 rapidly increases telomere length, yielding important information about the role of these proteins in telomere biology. PMID: 24840609
- Phosphorylation of synaptic GTPase-activating protein (synGAP) by Ca2+/calmodulin-dependent protein kinase II (CaMKII) and cyclin-dependent kinase 5 (CDK5) alters the ratio of its GAP activity toward Ras and Rap GTPases. PMID: 25533468
- crystal structure of an active, GTP-bound GTPase domain of Rap1 in complex with the Ras association (RA)-pleckstrin homology (PH) structural module of RIAM at 1.65 A, is reported. PMID: 24287201
- a model by which the small GTPase Rap1 could regulate aES assembly/remodelling. PMID: 24719879
- basal levels of Rap1 activity holds up cell adhesion, whereas sequential regulation of C3G and GAP by IGF-IR reverses the labile Rap1 function from supporting adhesion to promoting migration. PMID: 25028810
- a Rap1A/beta1 integrin pathway, activated downstream of G-protein-coupled receptor stimulation and RhoA, in glioblastoma cell proliferation. PMID: 24790104
- optimal cell migration is associated with cycles of Rap1 activation, membrane egress, and inactivation, and requires the regulated phosphorylation of Rap1 by PKA PMID: 23946483
- these studies extend of alpha2C-ARs is mediated through Rap1-filamin signaling. Perturbation of this signaling pathway may lead to alterations in alpha2C-AR trafficking and physiological function. PMID: 23864608
- These data show that HEG1 can recruit the Rap1-KRIT complex to the plasma membrane. PMID: 23814056
- Data indicate that Epac1-Rap1A-RhoA-ROCK signaling affects Cl- secretion via effects on the apical expression of KCNN4c channels. PMID: 23720748
- endothelial barrier resistance is determined by the combined antagonistic actions of Rap1 and Rap2 PMID: 23469100
- High Rap1A expression is associated with invasive breast tumors. PMID: 23405264
- the Aurora-A/Rap-1A pathway is associated with survival, tumor progression, and metastasis of oral cavity squamous cell carcinoma patients. PMID: 23219753
- Syndecan-1 restrains migration in lung epithelium by activating Rap1 to slow focal adhesion disassembly. PMID: 22899717
- Studies indicate that Radil regulates neutrophil adhesion and motility by linking Rap1 to beta2-integrin activation. +++ ERROR +++ studies establish that Radil regulates neutrophil adhesion and motility by linking Rap1 to beta2-integrin activation. PMID: 23097489
- Constitutive Rap1 activation in human prostate tumor cells promotes hypoxic induction of VEGF and angiogenesis, and PKA antagonizes this effect. PMID: 23166790
- This article discusses the role of RAP1 and Rap1GAP in squamous cell carcinoma of the head and neck progression in the context of a microRNA-oncogene-tumor suppressor gene axis. PMID: 22684501
- the PI3 kinase/Rap1 pathway is intrinsically impaired in platelets from JAK2V617F-positive essential thrombocythemia patients, resulting in diminished thrombin and thrombopoietin-mediated integrin alpha(IIb)beta(3) activation PMID: 23243278
- It was shown that the kinesin KIF14 associates with the PDZ domain of Radil and negatively regulates Rap1-mediated inside-out integrin activation by tethering Radil on microtubules. PMID: 23209302
- High RAP1A expression is associated with esophageal squamous cell carcinoma. PMID: 22859270
- The identification of a miR-337-3p as a modulator of cellular response to taxanes, and STAT3 and RAP1A as regulatory targets which mediate that response. PMID: 22723956
- Abl family kinases modulate T cell-mediated inflammation and chemokine-induced migration through the adaptor HEF1 and the GTPase Rap1. PMID: 22810897
- Structural basis for small G protein effector interaction of Ras-related protein 1 (Rap1) and adaptor protein Krev interaction trapped 1 (KRIT1) PMID: 22577140
- cAMP induces a conformational change in Epac1 that enables DEP domain-mediated binding to phosphatidic acid, resulting in the tethering of Epac1 at the plasma membrane and subsequent activation of Rap PMID: 22343288
- farnesylthiosalicylic acid-amide inhibits contact sensitivity through Rap1 inhibition PMID: 21716322
- Epac1 is expressed in human neutrophils and is involved in cAMP-dependent regulation of Rap1. However, the loading of GTP on Rap1 per se is not sufficient to promote activation of beta2 integrins. PMID: 21750123
- These results demonstrate a distinct physiological role for Ser(756) of beta2 integrin, in conjunction with the actions of talin and Rap1, during alphaMbeta2 activation in macrophages. PMID: 21605078
- For the first time, a role has been shown for Rap1-mediated association between adherens junction and tight junction complexes in the 1-palmitoyl-2-arachidonoyl-sn-glycero-3-phosphorylcholine-induced pulmonary vascular endothelial cell barrier protection. PMID: 21520057
- Rap1A binds the tumor suppressor Ras association domain family 1A (RASSF1A) in a manner that is regulated by phosphorylation of RASSF1A PMID: 21468893
- cAMP-responsive Rap1 guanine nucleotide exchange factor, Epac, induces smooth muscle relaxation by down-regulation of RhoA activity PMID: 21454546
- PA and Rap1 cooperatively regulate RA-RhoGAP activity for promoting neurite outgrowth. PMID: 21169361
- Results indicate that guanine nucleotide exchange and interactions with SmgGDS splice variants can regulate the entrance and passage of PBR-possessing small GTPases through the prenylation pathway. PMID: 20709748
顯示更多
收起更多
-
亞細胞定位:Cell membrane; Lipid-anchor. Cytoplasm. Cytoplasm, perinuclear region. Cell junction. Early endosome.
-
蛋白家族:Small GTPase superfamily, Ras family
-
數據庫鏈接:
Most popular with customers
-
-
YWHAB Recombinant Monoclonal Antibody
Applications: ELISA, WB, IHC, IF, FC
Species Reactivity: Human, Mouse, Rat
-
Phospho-YAP1 (S127) Recombinant Monoclonal Antibody
Applications: ELISA, WB, IHC
Species Reactivity: Human
-
-
-
-
-